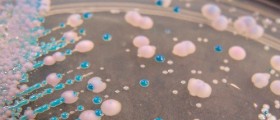

CANT BE PREGNANT TUBES TIED, BUT I HAVE A PAIN IN MY LOWER GROIN AREA, HURTS TO PEE, PRIOR TO THIS I FELT LIKE I HAD TO PEE ALL THE TIME I GOT SOME DISCHARGE WHITE AND A LITTLE BLOODY
IT HURTS TO PEE I CANT WALK RIGHT
IT HURTS TO PEE I CANT WALK RIGHT
Loading...
hmm.. it could be a yeast infection. A friend of mine had gotten an extreme case of one and had EXTREME pain during urination, frequent urination, white clumpy discharge, and some light red discharge. Other signs to look for would be itching in that area and discharge that literally smells like yeast (bread or beer). There are tests now to check to see if it is actually a yeast infection, as well as creams to treat it. (Vagisil, Monistat)
I would also be concerned if you have an STD. STDs show similar symptoms but you dont have many symptoms listed so my guess is it wouldnt be that. Another thing it could be is a bacterial infection or a UTI (urinary tract infection). There are several things that this could be so i would see a doctor ASAP because it could be potentially serious.
I would also be concerned if you have an STD. STDs show similar symptoms but you dont have many symptoms listed so my guess is it wouldnt be that. Another thing it could be is a bacterial infection or a UTI (urinary tract infection). There are several things that this could be so i would see a doctor ASAP because it could be potentially serious.
Loading...
Im having lower pains in my stomach bloody discharge and little pain when I pee im really scared cuz I never had this problem b4 I had a std 3months ago but im cured from that someone plz help me I really would appreciate it thanks
Loading...